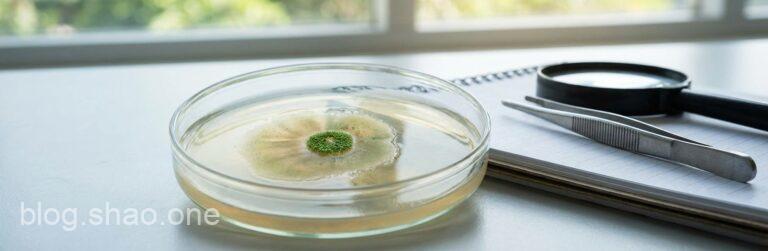
浴火重生的生物奇蹟:破解困擾科學界 50 年的「細胞再生」之謎! 10 1766750758460

【科技新知】阿茲海默症有解了?西北大學研發「NU-9」黑科技,要在症狀出現前先發制人!

科技與自然的神級跨界!日本雨蛙腸道竟藏有「抗癌神藥」?

科技宅、社畜必看!名醫私藏「抗焦慮食物清單」:用吃的高效重開機,告別腦霧與心悸

【經典回歸】聖誕夜的「回憶殺」!《太空侵略者》重返 PS5/PS4,見證遊戲史的傳奇里程碑

拋開 3A 大作的包袱!2026 年我最期待的,竟是這款讓你「鑽車縫」的療癒小品

效能狂飆 80%?Windows 隱藏版「神級」登錄檔密技,讓你的 NVMe SSD 像吃了大補丸!

三星三摺疊機慘遭「滑鐵盧」?耐用度測試驚現致命傷,難道只是「華而不實」的昂貴玩具?

2025 遊戲圈年終期末測驗!Atlus 大老私藏名單揭曉,這幾款神作你還沒玩過就落伍了?
浴火重生的生物奇蹟:破解困擾科學界 50 年的「細胞再生」之謎!

誰說真金不怕火煉?科學家「不小心」讓黃金變身,跌破全球化學界眼鏡!
